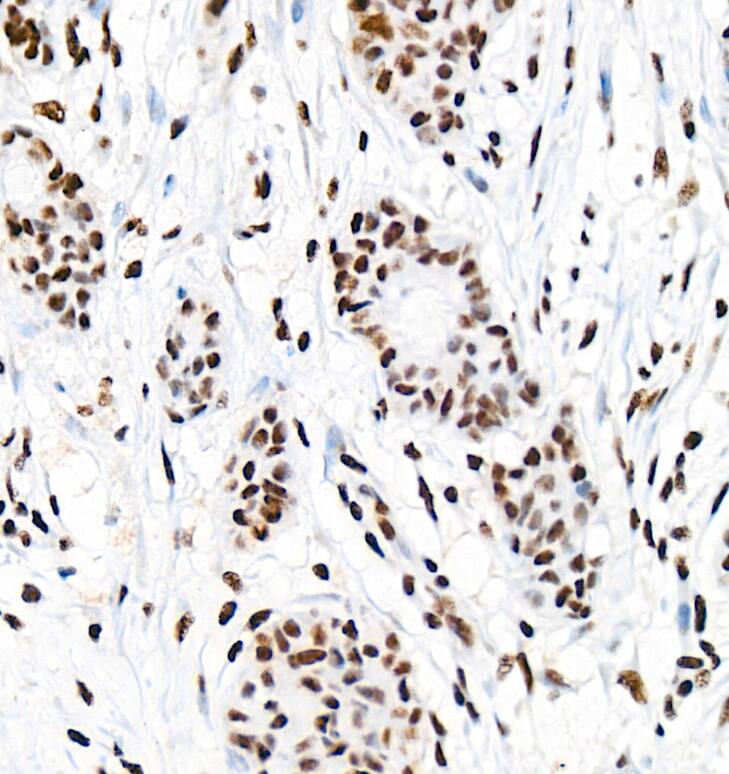
EFTUD2 Antibody (2Z1K3)

EFTUD2 Antibody (2Z1K3)
Novus Biologicals, part of Bio-Techne | Catalog # NBP3-33507

Key Product Details
Species Reactivity
Human, Mouse, Rat
Applications
Immunohistochemistry, Immunohistochemistry-Paraffin, Western Blot, ELISA, Immunocytochemistry/ Immunofluorescence, Immunoprecipitation
Label
Unconjugated
Antibody Source
Monoclonal Rabbit IgG Clone # 2Z1K3
Concentration
Please see the vial label for concentration. If unlisted please contact technical services.
Product Specifications
Immunogen
Recombinant fusion protein containing a sequence corresponding to amino acids 1-205 of human EFTUD2 (NP_004238.3).
Sequence:
MDTDLYDEFGNYIGPELDSDEDDDELGRETKDLDEMDDDDDDDDVGDHDDDHPGMEVVLHEDKKYYPTAEEVYGPEVETIVQEEDTQPLTEPIIKPVKTKKFTLMEQTLPVTVYEMDFLADLMDNSELIRNVTLCGHLHHGKTCFVDCLIEQTHPEIRKRYDQDLCYTDILFTEQERGVGIKSTPVTVVLPDTKGKSYLFNIMDT
Sequence:
MDTDLYDEFGNYIGPELDSDEDDDELGRETKDLDEMDDDDDDDDVGDHDDDHPGMEVVLHEDKKYYPTAEEVYGPEVETIVQEEDTQPLTEPIIKPVKTKKFTLMEQTLPVTVYEMDFLADLMDNSELIRNVTLCGHLHHGKTCFVDCLIEQTHPEIRKRYDQDLCYTDILFTEQERGVGIKSTPVTVVLPDTKGKSYLFNIMDT
Clonality
Monoclonal
Host
Rabbit
Isotype
IgG
Theoretical MW
109 kDa.
Disclaimer note: The observed molecular weight of the protein may vary from the listed predicted molecular weight due to post translational modifications, post translation cleavages, relative charges, and other experimental factors.
Disclaimer note: The observed molecular weight of the protein may vary from the listed predicted molecular weight due to post translational modifications, post translation cleavages, relative charges, and other experimental factors.
Description
Novus Biologicals Rabbit EFTUD2 Antibody (2Z1K3) (NBP3-33507) is a monoclonal antibody validated for use in IHC, WB, ELISA, ICC/IF and IP. All Novus Biologicals antibodies are covered by our 100% guarantee.
Scientific Data Images for EFTUD2 Antibody (2Z1K3)
NBP3-33507-EFTUD2 Antibody (2Z1K3)
Analysis of paraffin-embedded Human breast cancer tissue using [KD Validated] EFTUD2 Rabbit mAb at a dilution of 1:1500 (40x lens). High pressure antigen retrieval performed with 0.01M Citrate Buffer (pH 6.0) prior to IHC staining.NBP3-33507-EFTUD2 Antibody (2Z1K3)-
Confocal imaging of NIH/3T3 cells using [KD Validated] EFTUD2 Rabbit mAb (dilution 1:200) followed by a further incubation with Cy3 Goat Anti-Rabbit IgG (H+L) (dilution 1:500) (Red). The cells were counterstained with alpha-Tubulin Mouse mAb (dilution 1:400) followed by incubation with ABflo® 488-conjugated Goat Anti-Mouse IgG (H+L) Ab (dilution 1:500) (Green). DAPI was used for nuclear staining (Blue). Objective: 100x.NBP3-33507-EFTUD2 Antibody (2Z1K3)-
Analysis of lysates from wild type (WT) and EFTUD2 knockdown (KD) HeLa cells using [KD Validated] EFTUD2 Rabbit mAb (at 1:5000 dilution incubated at room temperature for 1.5 hours.Secondary antibody: HRP-conjugated Goat anti-Rabbit IgG (H+L) at 1:10000 dilution.Lysates/proteins: 25 μg per lane.Blocking buffer: 3% nonfat dry milk in TBST.Detection: ECL Basic Kit. Exposure time: 1s.Applications for EFTUD2 Antibody (2Z1K3)
Application
Recommended Usage
ELISA
Recommended starting concentration is 1 ug/mL
Immunocytochemistry/ Immunofluorescence
1:200 - 1:800
Immunohistochemistry
1:1000 - 1:4000
Immunohistochemistry-Paraffin
1:1000 - 1:4000
Immunoprecipitation
0.5μg-4μg antibody for 400μg-600μg extracts of whole cells
Western Blot
1:2000 - 1:30000
Formulation, Preparation, and Storage
Purification
Affinity purified
Formulation
PBS (pH 7.3), 50% glycerol, 0.05% BSA
Preservative
0.05% Proclin 300
Concentration
Please see the vial label for concentration. If unlisted please contact technical services.
Shipping
The product is shipped with polar packs. Upon receipt, store it immediately at the temperature recommended below.
Stability & Storage
Store at -20C. Avoid freeze-thaw cycles.
Background: EFTUD2
Alternate Names
DKFZp686E24196, elongation factor Tu GTP binding domain containing 2, Elongation factor Tu GTP-binding domain-containing protein 2, FLJ44695, hSNU114, KIAA0031U5-116 kDa, SNRP116, Snrp116,116 kDa U5 small nuclear ribonucleoprotein component, Snu114, SNU114 homolog, U5 snRNP specific protein, 116 kD, U5 snRNP-specific protein, 116 kD, U5 snRNP-specific protein, 116 kDa, U5-116KD
Gene Symbol
EFTUD2
Additional EFTUD2 Products
Product Specific Notices for EFTUD2 Antibody (2Z1K3)
This product is for research use only and is not approved for use in humans or in clinical diagnosis. Primary Antibodies are guaranteed for 1 year from date of receipt.
Loading...
Loading...
Loading...
Loading...